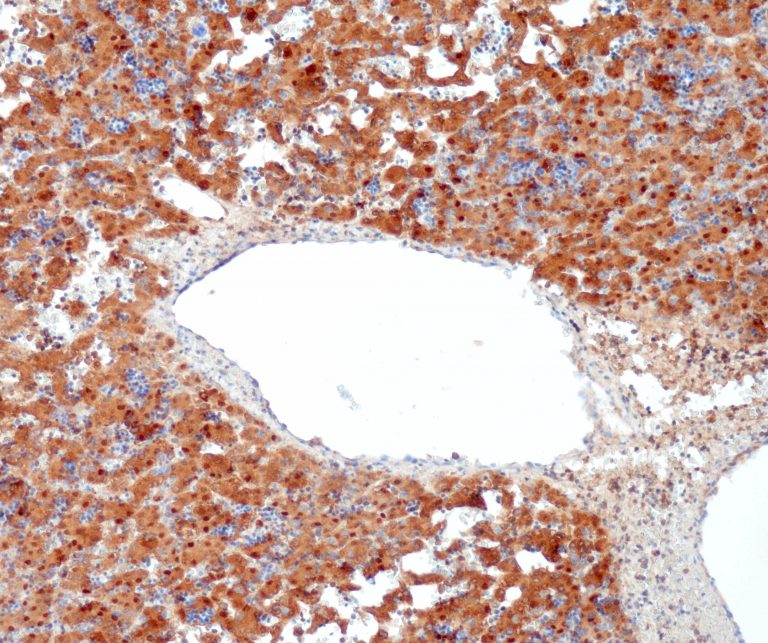
image
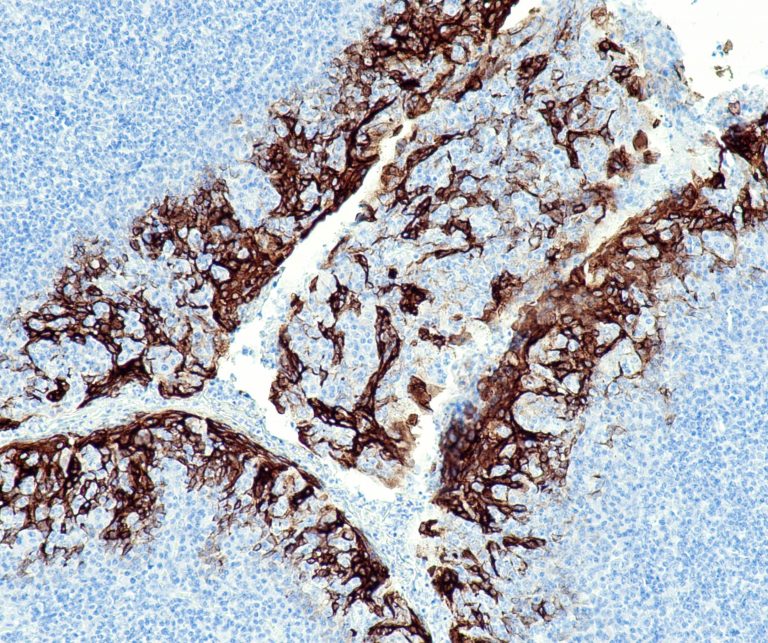
image
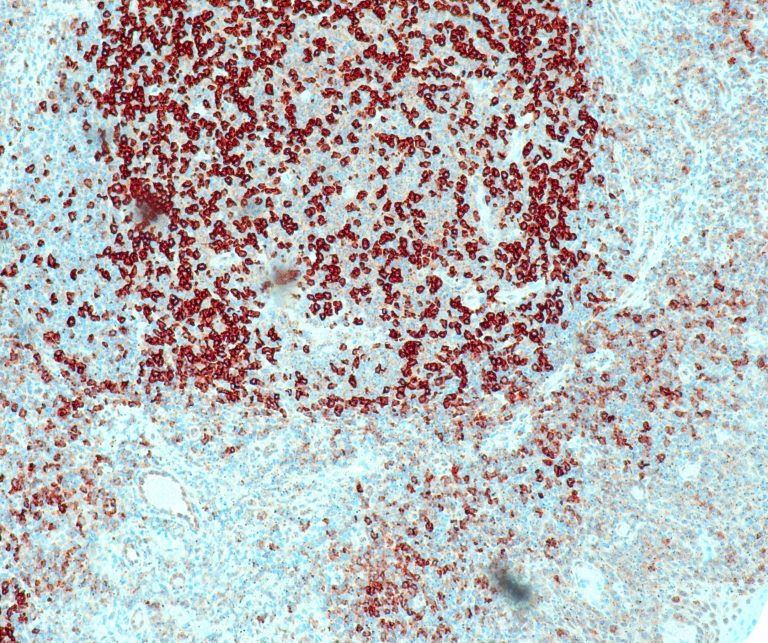
image
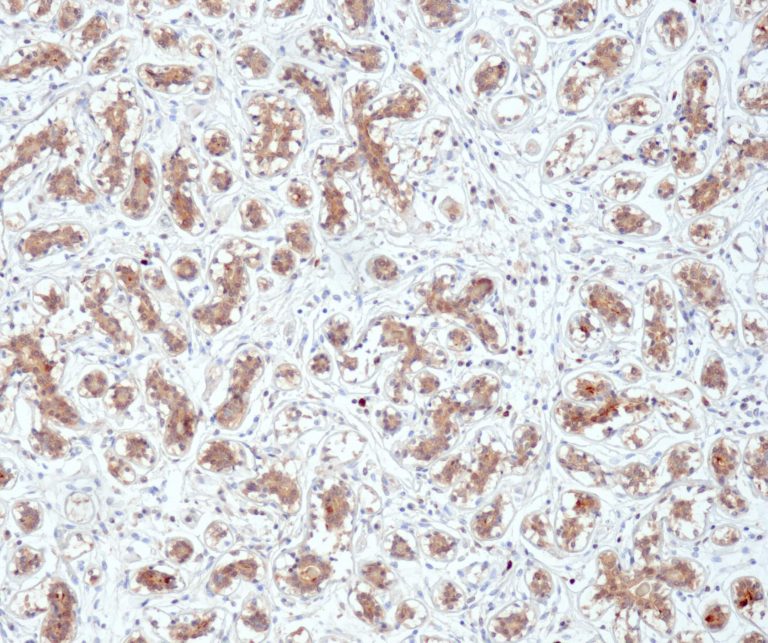
image
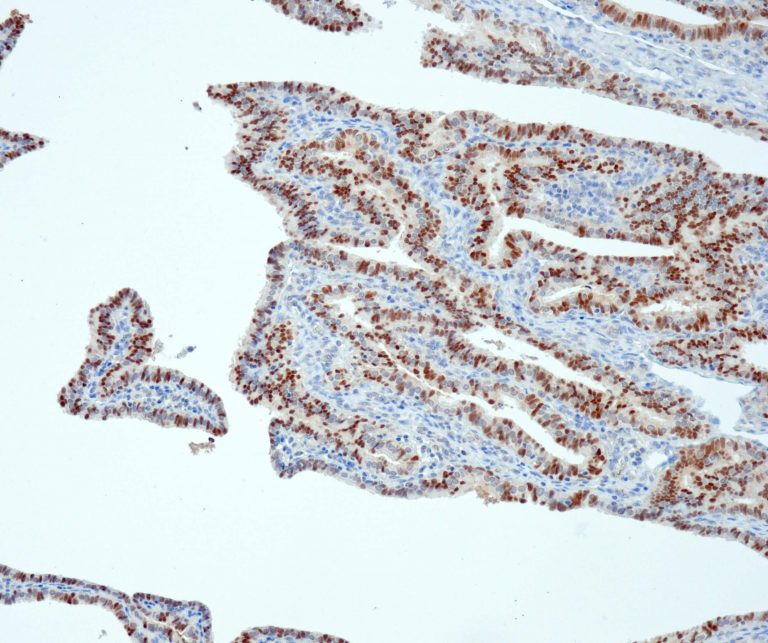
image
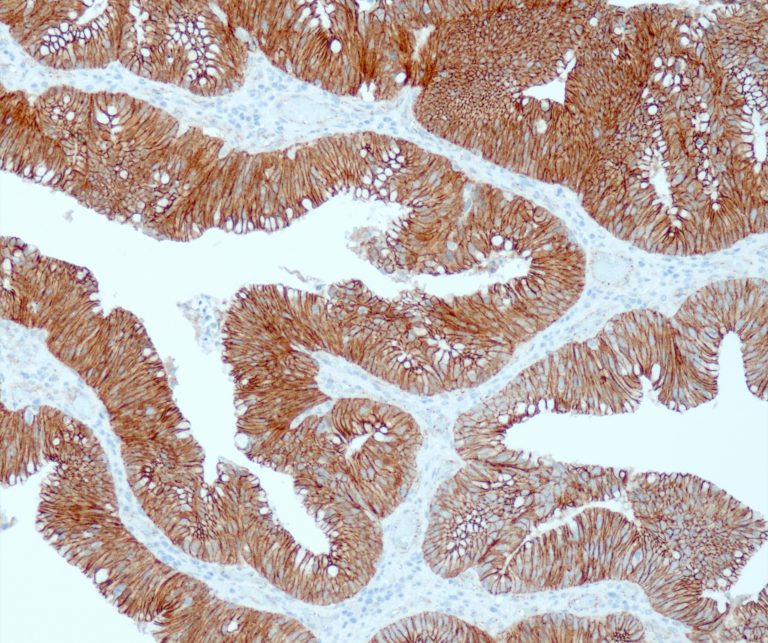
image
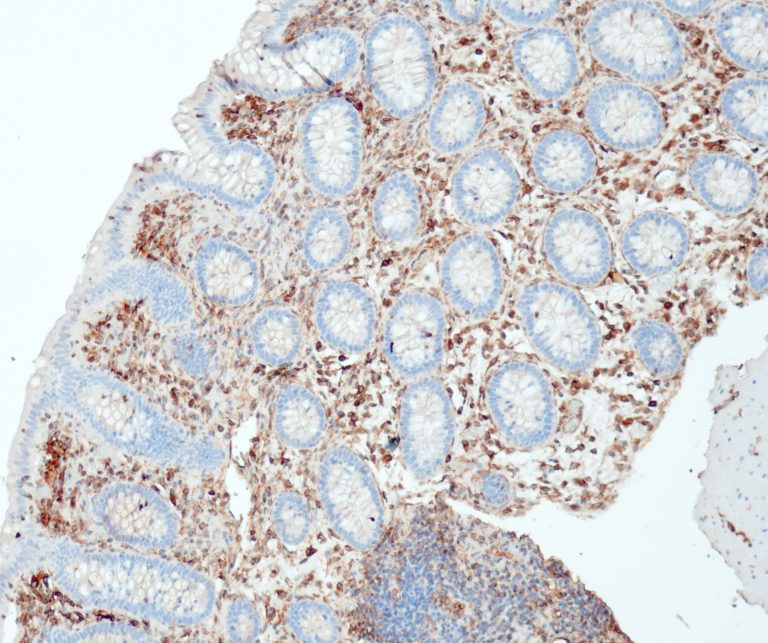
image

This is a popup message!


OUR HEALTHCARE EXPERTISE
Establishing New Standards in Research and Clinical Care
FUTURES INDIA PVT LTD boasts a world-class management team with extensive expertise in the Pharma, Medical Devices, Diagnostics, Life Sciences, and Healthcare Industries in India. Our team's deep understanding of market dynamics enables us to provide tailored solutions that drive innovation and growth. We are committed to fostering partnerships that enhance healthcare delivery and improve patient outcomes across the region. Together, we strive to navigate the complexities of the industry and empower our clients to achieve their strategic goals.
Our Special Features
We provide distinctive features that distinguish us in the healthcare landscape. With our advanced research methodologies and a committed team of experts, we deliver innovative solutions specifically tailored to our clients' needs. Discover unmatched support and insights that promote excellence in research and clinical care.


Vascular Pathology

Gastrointestinal (GI) Pathology

General Marker

Breast Pathology

Endocrine Pathology

Gynecological Pathology

Neuropathology

Infection Markers

Lung Pathology

Urinary Tract Pathology

Transplantation Pathology

Soft Tissue Pathology

Hematopathology
Our Clientele